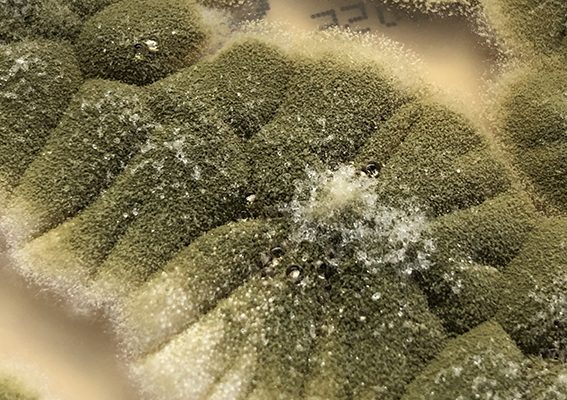

может помочь
Шиитаке: Древний гриб для современного здоровья Мы‚ как люди‚ стремящиеся к здоровому образу жизни‚ все чаще обращаем внимание на природные
Шиитаке: Древний гриб для современного здоровья Мы‚ как люди‚ стремящиеся к здоровому образу жизни‚ все чаще обращаем внимание на природные
Шиитаке: Древний гриб для современного здоровья Мы, как люди, стремящиеся к здоровому образу жизни, все чаще обращаем внимание на природные источники силы и долголетия.
Шиитаке: Древний гриб для современного здоровья Мы, как люди, стремящиеся к здоровому образу жизни, все чаще обращаем внимание на природные источники силы
Шиитаке: Древний гриб для современного здоровья Мы, как люди, стремящиеся к здоровому образу жизни, все чаще обращаем внимание на природные источники силы и долголетия.
Шиитаке: Древний гриб для современного здоровья Мы, как люди, стремящиеся к здоровому образу жизни, все чаще обращаем внимание на природные источники силы и долголетия.
Шиитаке: Древний гриб для современного здоровья Мы, как люди, стремящиеся к здоровому образу жизни, все чаще обращаем внимание на природные источники силы и долголетия.
Шиитаке: Древний гриб для современного здоровья Мы‚ как люди‚ стремящиеся к здоровому образу жизни‚ все чаще обращаем внимание на природные
Шиитаке: Древний гриб для современного здоровья Мы‚ как люди‚ стремящиеся к здоровому образу жизни‚ все чаще обращаем внимание на природные
Шиитаке: Древний гриб для современного здоровья Мы, как люди, стремящиеся к здоровому образу жизни, все чаще обращаем внимание на природные источники силы и исцеления.